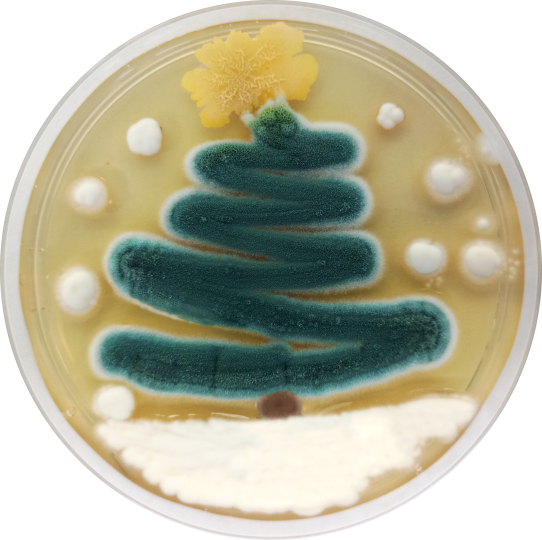
Mikrobiologia

Kolekcja Kultur Drobnoustrojów Przemysłowych
Odkryj różnorodność mikroorganizmów o najwyższej jakości, spełniających surowe standardy przemysłowe.
🎄
🎁
⭐
✨
✨Wesołych Świąt
Bożego Narodzenia
⭐
Niech ten wyjątkowy czas będzie pełen radości, ciepła i prawdziwej świątecznej magii.
Życzymy spokojnych, rodzinnych chwil przy świątecznym stole, serdecznych uśmiechów bliskich osób oraz nadziei na lepsze jutro.
Oby Nowy Rok przyniósł same sukcesy, spełnienie marzeń i niezapomniane chwile!
Z najlepszymi życzeniami
Zespół KKP
🎄🎁⭐
Nasze usługi
Identyfikacja szczepów
Profesjonalna identyfikacja i charakterystyka szczepów drobnoustrojów.
Dowiedz się więcejPrzechowywanie kultur
Bezpieczne i długoterminowe przechowywanie kultur mikroorganizmów.
Przeglądaj katalog